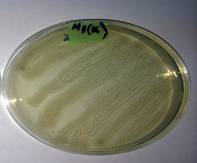

Экология. Экологический
мониторинг
Кенжебаева З.Б., Оразбаева Р.С., Масалимов Ж.К.
Евразийский национальный
университет им. Л.Н.Гумилева, Казахстан
Изучение резистентности микроорганизмов расщепляющих СПАВ на
негативные факторы окружающей среды.
За последние
более чем 50 лет появилась большая группа органических соединений, которые
создали дополнительную проблему, связанную с загрязнением вод. Это
синтетические поверхностно-активные вещества (СПАВ) или детергенты. Возросшая
потребность в СПАВ - ах на промышленных предприятиях, а также их использование
в быту приводит к увеличению его содержания в водоемах.
В настоящее время
поступление СПАВ в окружающую среды ежегодно увеличивается (в зависимости от
класса ПАВ), приблизительно на 2-5% [1]. Спектр биологических эффектов,
вызываемых ПАВ, широк и охватывает практически все основные блоки и трофические
уровни в водных экосистемах [2].
Повышенный
уровень СПАВ в водоемах оказывает негативное воздействие на гидробионты,
физико-химические и органолептические показатели воды Известно, что многие СПАВы
крайне медленно разрушаются в результате естественного окисления и
биодеградации [3]. В процессе самоочищения воды участвуют
практически все группы гидробионтов, включая микроорганизмы. Роль
микроорганизмов в этом процессе была исследована многими исследователями. В
работах [С.А.Остроумова, Ставская С.С.] сформулирована концепция
полифункциональной роли гидробионтов (и водной биоты в целом) в очищении воды
водных экосистем от загрязнителей. На сегодняшний день поиск микроаргонизмов способных к
активному разложению СПАВов и соответсвенно изучение их биохимических свойств до
сих пор являются актуальными.
Данная работа посвящена изучению
резистентности выделенных нами СПАВ-деградирующих микроорганизмов к таким
абиотическим факторам среды как температура,
УФ-радиация и рН среды.
Материалы и
методы.
Из стиральных машин студенческой прачечной нами
было выделено 4 штамма микроорганизмов, которых мы условно обозначили как - М1, М2, М3 и М4. Все микроорганизмы были протестированы
на способность расти на питательных средах при различных концентрациях СПАВ
(0.5, 1, 2, 3, 5 и 10%). В качестве СПАВ нами использовался коммерческие
стиральные порошки торговых марок «Ариель» и «Миф». При концентрации СПАВ 10%,
из 4 штаммов наилучшие ростовые свойства показал штамм М1. Поэтому последующие
работы проводились с использованием только этого штамма. Культивирование микроорганизмов проводили на жидкой и твердой питательных средах LB (Amresco). Видовая идентификация штамма
Micrococcus luteus Sint.M1 была проведена с помощью
определителя Берджи.
УФ-облучение проводилось с помощью УФ-облучателя
().
Результаты
и обсуждение.
Нами была
изучена температурная устойчивость микроорганизмов в диапазоне от +4°С до + 65°С. Результаты
представлены в таблице 1 и рисунках 1-2.
Микроорганизмы проявили оптимальные ростовые свойства при температуре от
+19°С до +45°С. При этом максимально бурный рост микроорганизмов
наблюдался при температуре +30°С. При температурах «+4°С»
и «+65°С» рост микроорганизмов не наблюдался (рисунок 1).
1 таблица
Рост бактерии при воздействии разного диапазона
температур
|
Температура, °С |
+4°С |
+19°С |
+30°С |
+45°С |
+65°С |
|
Бактериальный
рост* |
- |
++ |
++++ |
+++ |
- |
|
* «-» - роста нет, «+» - слабый рост,
«++» - умеренный рост, «+++» -
хороший рост, «++++» - обильный рост. |
|||||

А Б



В Г Д
Рис.
1. Температурная устойчивость бактерии в
диапозоне от +4°С до + 65°С:
А – контроль; Б – рост при + 65°С; В – рост при +45°С; Г – рост при
+19°С; Д – рост
при температуре +4°С.
Нами была
изучена выживаемость микроорганизмов к воздействию УФ-облучения. Результаты
представлены в таблице 2. Облучение
проводили в чашке Петри на расстоянии 10 см. Суточная бактериальная культура
была облучена в течение 5, 10, 20 и 30 минут. В качестве контроля
использовались необлученные микроорганизмы. После облучения микроорганизмы
выращивались на плотной питательной среде LB в течение суток при температуре 30°C в термостате ТС-80.
2 таблица
Рост бактерии после облучения
|
Время облучения, мин |
5 |
10 |
20 |
30 |
|
Бактериальный рост* |
+ |
+ |
- |
- |
|
* «-» -
роста нет, «+» - слабый рост, «++» - умеренный
рост, «+++» - хороший рост, «++++» - обильный рост. |
||||
Также было изучено влияние рН
среды выживаемость
В
эксперименте наблюдалась динамика роста пробы «М1» в кислотно-щелочной среде. С помощью pH метра в
жидкой питательной среде уровень pH был доведен
до нужного уровня для кислой среды с добавлением кислоты H2SO4, для щелочной среды с добавлением щелочи гидроксида
натрия (NaOH). Для эксперимента были выбраны следующие значения: pH3; pH5; pH5,5; pH6; pH6,5; pH6,9; pH8,5; pH10. После доведения уровня pH до нужных значений в питательной
среде, среду стерилизовали в автоклаве. После стерилизации в среду высеили
суточную бактерию и установили на качалку. Далее были проведены замеры
оптической плотности.
При значениях pH5; pH5,5; pH6; pH6,5; pH6,9; pH8,5 рост бактерии был на максимальном уровне уже на 28 часов
измерений. Далее рост был стабильным до измерения 49 часов при последующих
измерениях наблюдался спад. При значениях pH3; pH10. рост был не стабильным, так как эти значения не
благоприятные для роста бактерий и далеко от оптимального уровня pH (рисунок 2).

Рис. 2. Динамика роста бактерии в кислотно-щелочной среде.
Выводы:
1.Бактерия устойчива к температурам 19C 30C 45C. При температурах
4С и 65С роста бактерии нет.
2.Бактерия не резистентная по отношению к
облучению. Малый рост наблюдался при облучении в течение 5 и 10 минутах. При 20
и 30 минутном облучении УФ роста нет. При таком длительном облучении рост
бактерии не возможен.
3.Не наблюдается динамика роста бактерии
при значениях pH3 и pH10. Так как это очень кислая и щелочная среда для
роста. Наиболее благоприятный для роста уровень «pH» pH5; pH5,5; pH6; pH6,5; pH6,9; pH8,5.
Литература:
1.Остроумов С.А. Биологическая активность
вод, содержащих ПАВ // Химия и технология воды. 1991.Т.13. № 3. С. 270-283
2. Остроумов С.А.
Биологические эффекты при воздействии поверхностно-активных веществ на
организмы. М.: МАКС-Пресс, 2001. 334 с
3. Ставская С.С., Удод В.М.,
Таранова Л.А., Кривец И.А. Микробиологическая очистка воды от
поверхностно-активных веществ. Киев: Наук. думка, 1988.184